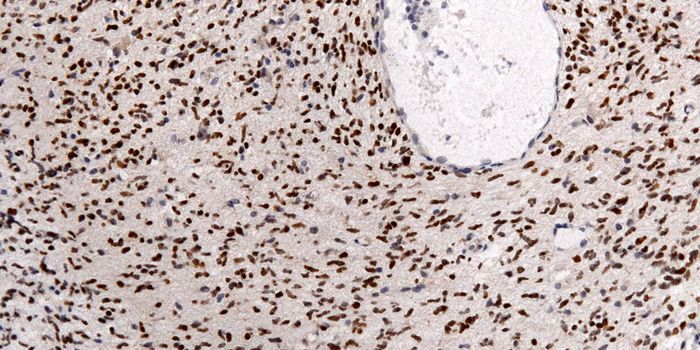
Algorithm Predicts Glioma Survival Better Than Specialists

Data visualization
Data visualization is an interdisciplinary field that deals with the graphic representation of data and/or information. It's thought to be a paticularly effective way of communicating large datasets, especially to more general audiences.
-
APR 04, 2018NeurosciencePicture a scene in which a cap with electrode sensors is fitted on to a person's scalp, connected to an electroencep ...Written By: Brenda Kelley KimMAR 23, 2018TechnologyThese wind turbines are designed to measure and deter encounters with protected birds.Written By: Julia TraversMAR 22, 2018NeuroscienceIt takes nine months for a baby to grow from a few cells to a full-term newborn and there’s a lot going on during ...Written By: Brenda Kelley KimMAR 15, 2018Clinical & Molecular DXFor people newly diagnosed with glioma, a lethal brain cancer, the most they can hope for is an accurate diagnosis, so d ...Written By: Kara MarkerMAR 09, 2018Chemistry & PhysicsResearchers from The State University of New York at Buffalo (UB) announced they have developed an innovative imaging me ...Written By: Daniel DuanMAR 08, 2018TechnologyAn estimated 253 million people live with some kind of vision impairment and might enjoy this new gaming option.Written By: Julia TraversMAR 06, 2018NeuroscienceUnderstanding the spoken word is probably one of the most complex tasks the human brain can perform. In regular conversa ...Written By: Brenda Kelley KimMAR 05, 2018VideosOuter space is a playground for scientific exploration, but it can be hard to visualize the data we capture. In most cas ...Written By: Anthony BouchardFEB 21, 2018Clinical & Molecular DXA new imaging option makes it possible to diagnose breast cancer with better accuracy, improved efficiency, and with mor ...Written By: Kara MarkerFEB 17, 2018TechnologyOn Feb. 15, 2018, Google filed two patents for radar-sensing remote control devices.Written By: Julia TraversFEB 07, 2018TechnologyStaff from prominent museums all over the globe come to CMA to learn about their cutting-edge and engaging exhibition st ...Written By: Julia TraversFEB 03, 2018MicrobiologyZika virus only impacts six to twelve percent of children born to infected mothers. Researchers are learning exactly why ...Written By: Carmen LeitchDEC 11, 2017Genetics & GenomicsAs we age and whenever tissue is damaged, cells divide and replace old ones. The DNA in the nucleus has to be accurately ...Written By: Carmen LeitchNOV 22, 2017Plants & AnimalsDolphin behavior may not be too far off from human behavior in some aspects, and contemporary scientific research is beg ...Written By: Anthony BouchardNOV 20, 2017NeuroscienceAs any neuroscientist will undoubtedly attest, if there were a way for researchers to be inside a brain, able to visuali ...Written By: Brenda Kelley KimNOV 08, 2017NeuroscienceWho hasn't wondered about the possibility of knowing exactly what someone else is thinking? If only we could underst ...Written By: Brenda Kelley KimOCT 19, 2017Cell & Molecular BiologyScientists are trying to reach out to the general public to help people understand more about the work that researchers ...Written By: Carmen LeitchSEP 24, 2017Cell & Molecular BiologyMysterious nanotubes are starting to get serious research attention, but little is known about their function.Written By: Carmen LeitchSEP 18, 2017NeuroscienceVirtual reality (VR) headsets are very popular with gamers. Being immersed in a different world and being able to intera ...Written By: Brenda Kelley KimSEP 17, 2017Cell & Molecular BiologyResearchers have found evidence that most tattoo inks contain tiny particles that can migrate away from the site of appl ...Written By: Carmen LeitchAUG 29, 2017Plants & AnimalsBirds can take incredibly long trips when foraging or migrating, but the hidden mechanisms behind how they find their wa ...Written By: Anthony BouchardJUL 31, 2017Cell & Molecular BiologyAfter developing new techniques, researchers find that what we have assumed about DNA organization may be wrong.Written By: Carmen LeitchJUL 12, 2017Cell & Molecular BiologyThere is incredible complexity within the sweat gland, and there has been a lack of extremely detailed information until ...Written By: Carmen LeitchJUL 11, 2017Health & MedicineEven in remission, cancer looms. Former cancer patients and their doctors are always on alert for metastatic tumors. Now ...Written By: The Scripps Research Institute (TSRI)
APR 04, 2018
Neuroscience
Picture a scene in which a cap with electrode sensors is fitted on to a person's scalp, connected to an electroencep
...
Written By:
Brenda Kelley Kim
MAR 23, 2018
Technology
These wind turbines are designed to measure and deter encounters with protected birds.
Written By:
Julia Travers
MAR 22, 2018
Neuroscience
It takes nine months for a baby to grow from a few cells to a full-term newborn and there’s a lot going on during
...
Written By:
Brenda Kelley Kim
MAR 15, 2018
Clinical & Molecular DX
For people newly diagnosed with glioma, a lethal brain cancer, the most they can hope for is an accurate diagnosis, so d
...
Written By:
Kara Marker
MAR 09, 2018
Chemistry & Physics
Researchers from The State University of New York at Buffalo (UB) announced they have developed an innovative imaging me
...
Written By:
Daniel Duan
MAR 08, 2018
Technology
An estimated 253 million people live with some kind of vision impairment and might enjoy this new gaming option.
Written By:
Julia Travers
MAR 06, 2018
Neuroscience
Understanding the spoken word is probably one of the most complex tasks the human brain can perform. In regular conversa
...
Written By:
Brenda Kelley Kim
MAR 05, 2018
Videos
Outer space is a playground for scientific exploration, but it can be hard to visualize the data we capture. In most cas
...
Written By:
Anthony Bouchard
FEB 21, 2018
Clinical & Molecular DX
A new imaging option makes it possible to diagnose breast cancer with better accuracy, improved efficiency, and with mor
...
Written By:
Kara Marker
FEB 17, 2018
Technology
On Feb. 15, 2018, Google filed two patents for radar-sensing remote control devices.
Written By:
Julia Travers
FEB 07, 2018
Technology
Staff from prominent museums all over the globe come to CMA to learn about their cutting-edge and engaging exhibition st
...
Written By:
Julia Travers
FEB 03, 2018
Microbiology
Zika virus only impacts six to twelve percent of children born to infected mothers. Researchers are learning exactly why
...
Written By:
Carmen Leitch
DEC 11, 2017
Genetics & Genomics
As we age and whenever tissue is damaged, cells divide and replace old ones. The DNA in the nucleus has to be accurately
...
Written By:
Carmen Leitch
NOV 22, 2017
Plants & Animals
Dolphin behavior may not be too far off from human behavior in some aspects, and contemporary scientific research is beg
...
Written By:
Anthony Bouchard
NOV 20, 2017
Neuroscience
As any neuroscientist will undoubtedly attest, if there were a way for researchers to be inside a brain, able to visuali
...
Written By:
Brenda Kelley Kim
NOV 08, 2017
Neuroscience
Who hasn't wondered about the possibility of knowing exactly what someone else is thinking? If only we could underst
...
Written By:
Brenda Kelley Kim
OCT 19, 2017
Cell & Molecular Biology
Scientists are trying to reach out to the general public to help people understand more about the work that researchers
...
Written By:
Carmen Leitch
SEP 24, 2017
Cell & Molecular Biology
Mysterious nanotubes are starting to get serious research attention, but little is known about their function.
Written By:
Carmen Leitch
SEP 18, 2017
Neuroscience
Virtual reality (VR) headsets are very popular with gamers. Being immersed in a different world and being able to intera
...
Written By:
Brenda Kelley Kim
SEP 17, 2017
Cell & Molecular Biology
Researchers have found evidence that most tattoo inks contain tiny particles that can migrate away from the site of appl
...
Written By:
Carmen Leitch
AUG 29, 2017
Plants & Animals
Birds can take incredibly long trips when foraging or migrating, but the hidden mechanisms behind how they find their wa
...
Written By:
Anthony Bouchard
JUL 31, 2017
Cell & Molecular Biology
After developing new techniques, researchers find that what we have assumed about DNA organization may be wrong.
Written By:
Carmen Leitch
JUL 12, 2017
Cell & Molecular Biology
There is incredible complexity within the sweat gland, and there has been a lack of extremely detailed information until
...
Written By:
Carmen Leitch
JUL 11, 2017
Health & Medicine
Even in remission, cancer looms. Former cancer patients and their doctors are always on alert for metastatic tumors. Now
...
Written By:
The Scripps Research Institute (TSRI)